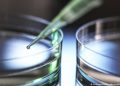

2022-12-27
Nuevo Mundo – 96.1
La organización humanitaria Médicos Sin Fronteras (MSF) alertó hoy (27.12.2022) del riesgo de que las crisis de inseguridad alimentaria que han observado este año en varios países de África, causadas por factores como el cambio climático, la inflación o los conflictos, estallen de manera «aguda» en 2023.Para MSF, «el año 2023 representa una continuación e incluso un posible agravamiento de las posibles crisis de inseguridad alimentaria que se han venido anunciando en 2022″, dijo este martes en una entrevista con EFE José Mas, director adjunto de operaciones de la organización.En este sentido, MSF pone el foco tanto sobre países del Sahel, como Mali, Burkina Faso o Nigeria, como en el Cuerno de África, incluyendo Somalia, Etiopía, Sudán y Sudán del Sur.Más de 35 millones de personas pasan hambre en África occidental y central actualmente a causa de la inseguridad persistente y el alza de los precios tras la guerra de Ucrania y la covid-19, según los últimos datos de las Naciones Unidas.Los países de África oriental, por su lado, atraviesan la peor sequía de los últimos cuarenta años, que afecta a unos 20,2 millones de menores en Etiopía, Kenia y Somalia, un número que se ha doblado en los últimos cinco meses, también según la ONU.»Estamos preparándonos para responder a posibles emergencias nutricionales que puedan ser derivadas de estas crisis alimentarias», señaló Mas.Aunque la organización no ha detectado de momento «situaciones generalizadas de hambruna» en un país, sí que alerta sobre «zonas localizadas con indicadores muy alarmantes».
La organización humanitaria Médicos Sin Fronteras (MSF) alertó hoy (27.12.2022) del riesgo de que las crisis de inseguridad alimentaria que han observado este año en varios países de África, causadas por factores como el cambio climático, la inflación o los conflictos, estallen de manera «aguda» en 2023.
Para MSF, «el año 2023 representa una continuación e incluso un posible agravamiento de las posibles crisis de inseguridad alimentaria que se han venido anunciando en 2022», dijo este martes en una entrevista con EFE José Mas, director adjunto de operaciones de la organización.
En este sentido, MSF pone el foco tanto sobre países del Sahel, como Mali, Burkina Faso o Nigeria, como en el Cuerno de África, incluyendo Somalia, Etiopía, Sudán y Sudán del Sur.
Más de 35 millones de personas pasan hambre en África occidental y central actualmente a causa de la inseguridad persistente y el alza de los precios tras la guerra de Ucrania y la covid-19, según los últimos datos de las Naciones Unidas.
Los países de África oriental, por su lado, atraviesan la peor sequía de los últimos cuarenta años, que afecta a unos 20,2 millones de menores en Etiopía, Kenia y Somalia, un número que se ha doblado en los últimos cinco meses, también según la ONU.
«Estamos preparándonos para responder a posibles emergencias nutricionales que puedan ser derivadas de estas crisis alimentarias», señaló Mas.
Aunque la organización no ha detectado de momento «situaciones generalizadas de hambruna» en un país, sí que alerta sobre «zonas localizadas con indicadores muy alarmantes».